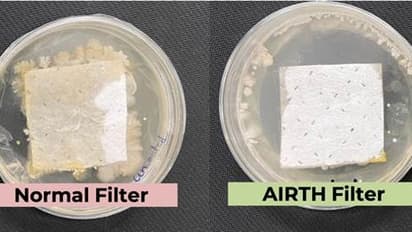
An innovative, green, novel antimicrobial air filtration technology can mitigate air-borne infection

একটি নতুন উপায়ে সৃষ্ট ‘এয়ার ফিল্টার’ (বাতাস শোধনকারী যন্ত্র) বাতাসে ভেসে থাকা জীবাণুগুলিকে নিষ্ক্রিয় করে রোগজীবাণু ছড়িয়ে পড়া বন্ধ করতে পারে শুধুমাত্র গ্রিন টি-তে পাওয়া সাধারণ উপাদানগুলি ব্যবহার করেই।
শিকাগো ইউনিভার্সিটির একটি রিপোর্ট অনুসারে, দূষিত বায়ু আমাদের আয়ু প্রশমিত করে দিতে পারে, যে পরিমাণে ভারতীয়রা তাঁদের জীবনের ৫-১০ বছর পর্যন্ত হারাতে পারেন, কারণ বায়ুবাহিত দূষিত পদার্থগুলি শ্বাসযন্ত্রের রোগের দিকে শরীরকে পরিচালিত করে, যা শারীরিক স্বাস্থ্যের পাশাপাশি মানসিক স্বাস্থ্যকেও বিরূপভাবে প্রভাবিত করে।
ইন্ডিয়ান ইনস্টিটিউট অফ সায়েন্স, বেঙ্গালুরু (IISc)-এর অধ্যাপক সূর্যসারথি বোস এবং অধ্যাপক কৌশিক চ্যাটার্জির নেতৃত্বে একটি গবেষণা দল জীবাণু-ধ্বংসকারী বায়ু শোধনকারী যন্ত্র তৈরি করেছেন, যা সাধারণত সবুজ চায়ে পাওয়া পলিফেনল এবং পলিকেশনিক পলিমারের মতো উপাদান ব্যবহার করে জীবাণুকে নিষ্ক্রিয় করতে পারে। এই 'সবুজ' উপাদানগুলি জীবাণুগুলিকে ধ্বংস করে দেয়।
এই যন্ত্র সৃষ্টির গবেষণাটি কোভিড মহামারী এবং SERB-টেকনোলজি ট্রান্সলেশন অ্যাওয়ার্ডস (SERB-TETRA) তহবিলের সময় বিজ্ঞান ও প্রকৌশল গবেষণা বোর্ড (SERB) থেকে বিশেষ অনুদান দ্বারা সমর্থিত হয়েছিল এবং এর উপর একটি পেটেন্ট দায়ের করা হয়েছে।
একই ফিলটার ক্রমাগত ব্যবহার করার ফলে, ফিল্টারগুলি বন্দী জীবাণুর প্রজননক্ষেত্রে পরিণত হয়। এই জীবাণুর বৃদ্ধি ফিল্টারের ছিদ্রগুলিকে বন্ধ করে দেয় এবং ফিল্টারের আয়ু কমিয়ে দেয়। এই জীবাণুগুলির পুনরুদ্ধার আশেপাশের লোকেদের সংক্রামিত করতে পারে। নতুন অ্যান্টিমাইক্রোবিয়াল এয়ার ফিল্টারগুলি NABL স্বীকৃত ল্যাবরেটরিতে পরীক্ষা করা হয়েছিল এবং ৯৯.২৪ শতাংশ দক্ষতার সাথে SARS-CoV-2 (ডেল্টা ভেরিয়েন্ট) নিষ্ক্রিয় করতে দেখা গেছে। এই প্রযুক্তিটি AIRTH-এ স্থানান্তর করা হয়েছে, একটি স্টার্টআপ যা বিদ্যমান জীবাণু-বর্ধমান বায়ু ফিল্টারগুলিকে বাণিজ্যিকীকরণের জন্য জীবাণু-ধ্বংসকারী বায়ু ফিল্টারগুলির সাথে প্রতিস্থাপন করছে।
যেহেতু এই উদ্ভাবনটি বায়ুবাহিত রোগজীবাণু দ্বারা সৃষ্ট রোগ প্রতিরোধ করতে পারে এমন অ্যান্টিমাইক্রোবিয়াল ফিল্টার তৈরি করার প্রতিশ্রুতি ধারণ করে, ২০২২ সালে এর জন্য একটি পেটেন্ট মঞ্জুর করা হয়েছে। আমাদের এসি, কেন্দ্রীয় নালী এবং এয়ার পিউরিফায়ারগুলিতে এই অভিনব অ্যান্টিমাইক্রোবিয়াল ফিল্টারগুলি বায়ুর বিরুদ্ধে আমাদের লড়াইয়ে গুরুত্বপূর্ণ ভূমিকা পালন করতে পারে৷ দূষণ এবং করোনাভাইরাসগুলির মতো বায়ুবাহিত রোগজীবাণুগুলির বিস্তার প্রশমিত করে।
আরও পড়ুন-
ডিসেম্বরের শহরে ভ্রমণকারীদের জন্য সুখবর, যাতায়াতে সুবিধা আনতে বাসের সংখ্যা বাড়াচ্ছে রাজ্য পরিবহণ দফতর
ব্যবহারকারীদের জন্য বড় বদল আনছে ইউটিউব, মন্তব্য করার আগে তা ক্ষতিকর কিনা, যাচাই করার সুযোগ
বাংলাদেশে শুরু হতে চলেছে মেট্রো রেল পরিষেবা, আর্থিক সঙ্কটে জাঁকজমকে কাটছাঁট হাসিনা সরকারের